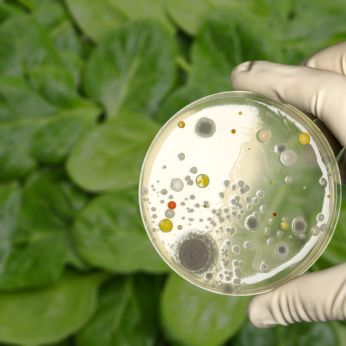

ILSI Europe
Exhibitors
Information
ILSI Europe provides science-driven solutions for the food and ingredients industry. We bring together industry leaders, world-class scientists, and regulators to address key challenges in food safety, nutrition, and sustainability. By fostering pre-competitive collaboration, we generate high-quality scientific insights that support innovation, product development, and regulatory compliance. Our expert-driven research helps companies stay ahead of emerging trends and make informed decisions backed by the latest science.
Let's connect at Fi Europe to explore how collaborative science can empower your business.
Visit our booth or join our panel on Wednesday, 3 December 2025, at 2:00 PM. With industry and academic experts, we'll share real-life examples of how collaborative science makes an impact and discuss critical areas where scientific consensus is needed. Your insights matter!
- Operations & Services